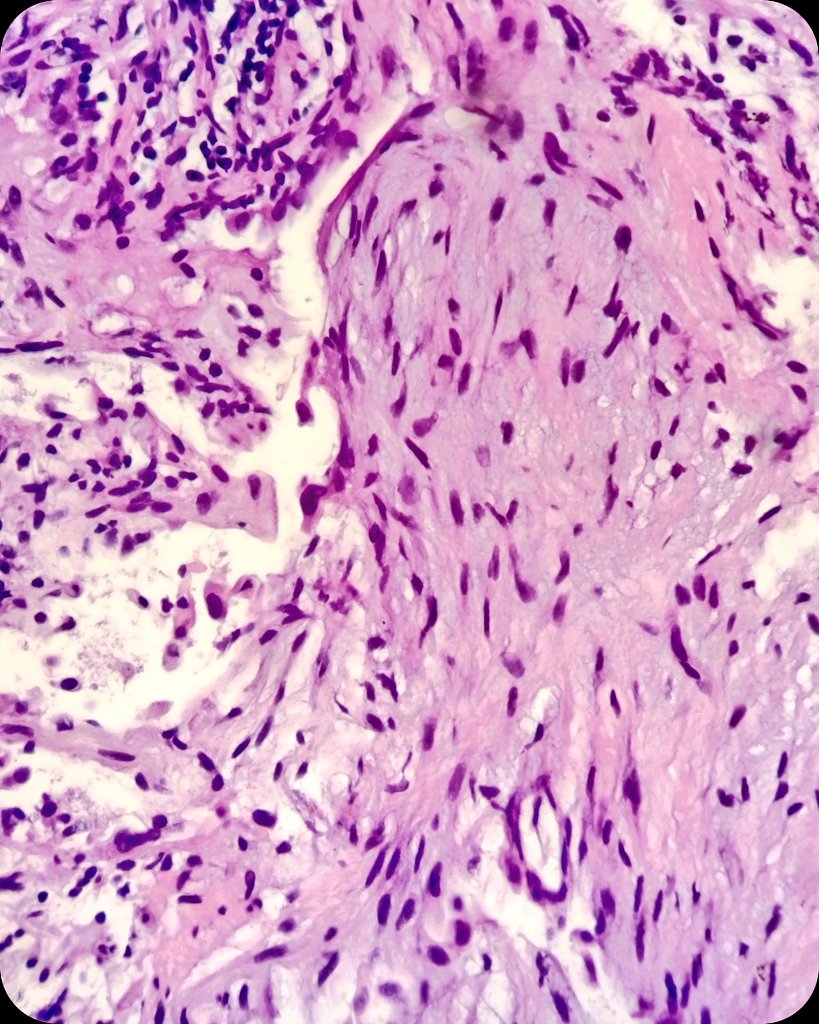
🫁 Interstitial lung pattern. Suspicious for UIP.
❄️ Transbronchial CryoBiopsy.
🔬 Fibroblastic foci.

#LungPath #PulmPath #PathX

Miguel Ariza Prota
@miguelariza83
Interventional Pulmonologist. Unidad Neumología Intervencionista del Hospital Universitario Central de Asturias. Oviedo #Neumologia #Cancer #linfoma #CRYOEBUS
ID: 1520901265030529024
01-05-2022 23:02:24
514 Tweet
1,1K Followers
1,1K Following






Preparados 💪💪para una edición m@s (XLVIII) del Curso Intensivo para Citotecnòlogos y Citopatòlogos en la Universidad Europea dirigido por la Dra Granados. Sociedad Española de Citología SEAP-IAP


👏🏽Excelente entrevista en La Nueva España a nuestro amigo Neumólogo Intervencionista Miguel Ariza Prota. Felicitaciones a todo el personal de EBUS del @HUCA.Encantados de hacer equipo diagnóstico. Esperando ofrecer el mejor servicio a los pacientes con los recursos adecuados.


🎯 Anything you imagine in IP… can be done through the WORKING CHANNEL of a single-use bronchoscope. 💥 Dare to prove it? 📍 Join us for the 2nd edition of Mastering the Working Channel Challenge by Miguel Ariza Prota and Javier Perez Pallares #Neumologia – powered by AMBU. Date very soon. #IPE






🚀 Junto a Miguel Ariza Prota , en COPE con José Ángel Cuadrado Roca en “Lo que viene” presentamos “ECHO-M-WAVES” microondas que “cocinan” tumores pulmonares desde dentro, sin cirugía guiados por ecografía. Ciencia española que abre vías y salva vidas. 🔬 🔥 cope.es/programas/lo-q…





Pleased to support another successful #CryoEBUS case at Nottingham University Hospitals with Dr. Abid & Dr. Khanna. The SonoTip® needle was key, streamlining the procedure through tract creation & sample gain. Thanks to Dr Rakesh K Panchal, Dr.Sudhir, Dr Miguel Ariza Prota for great teaching/insights.